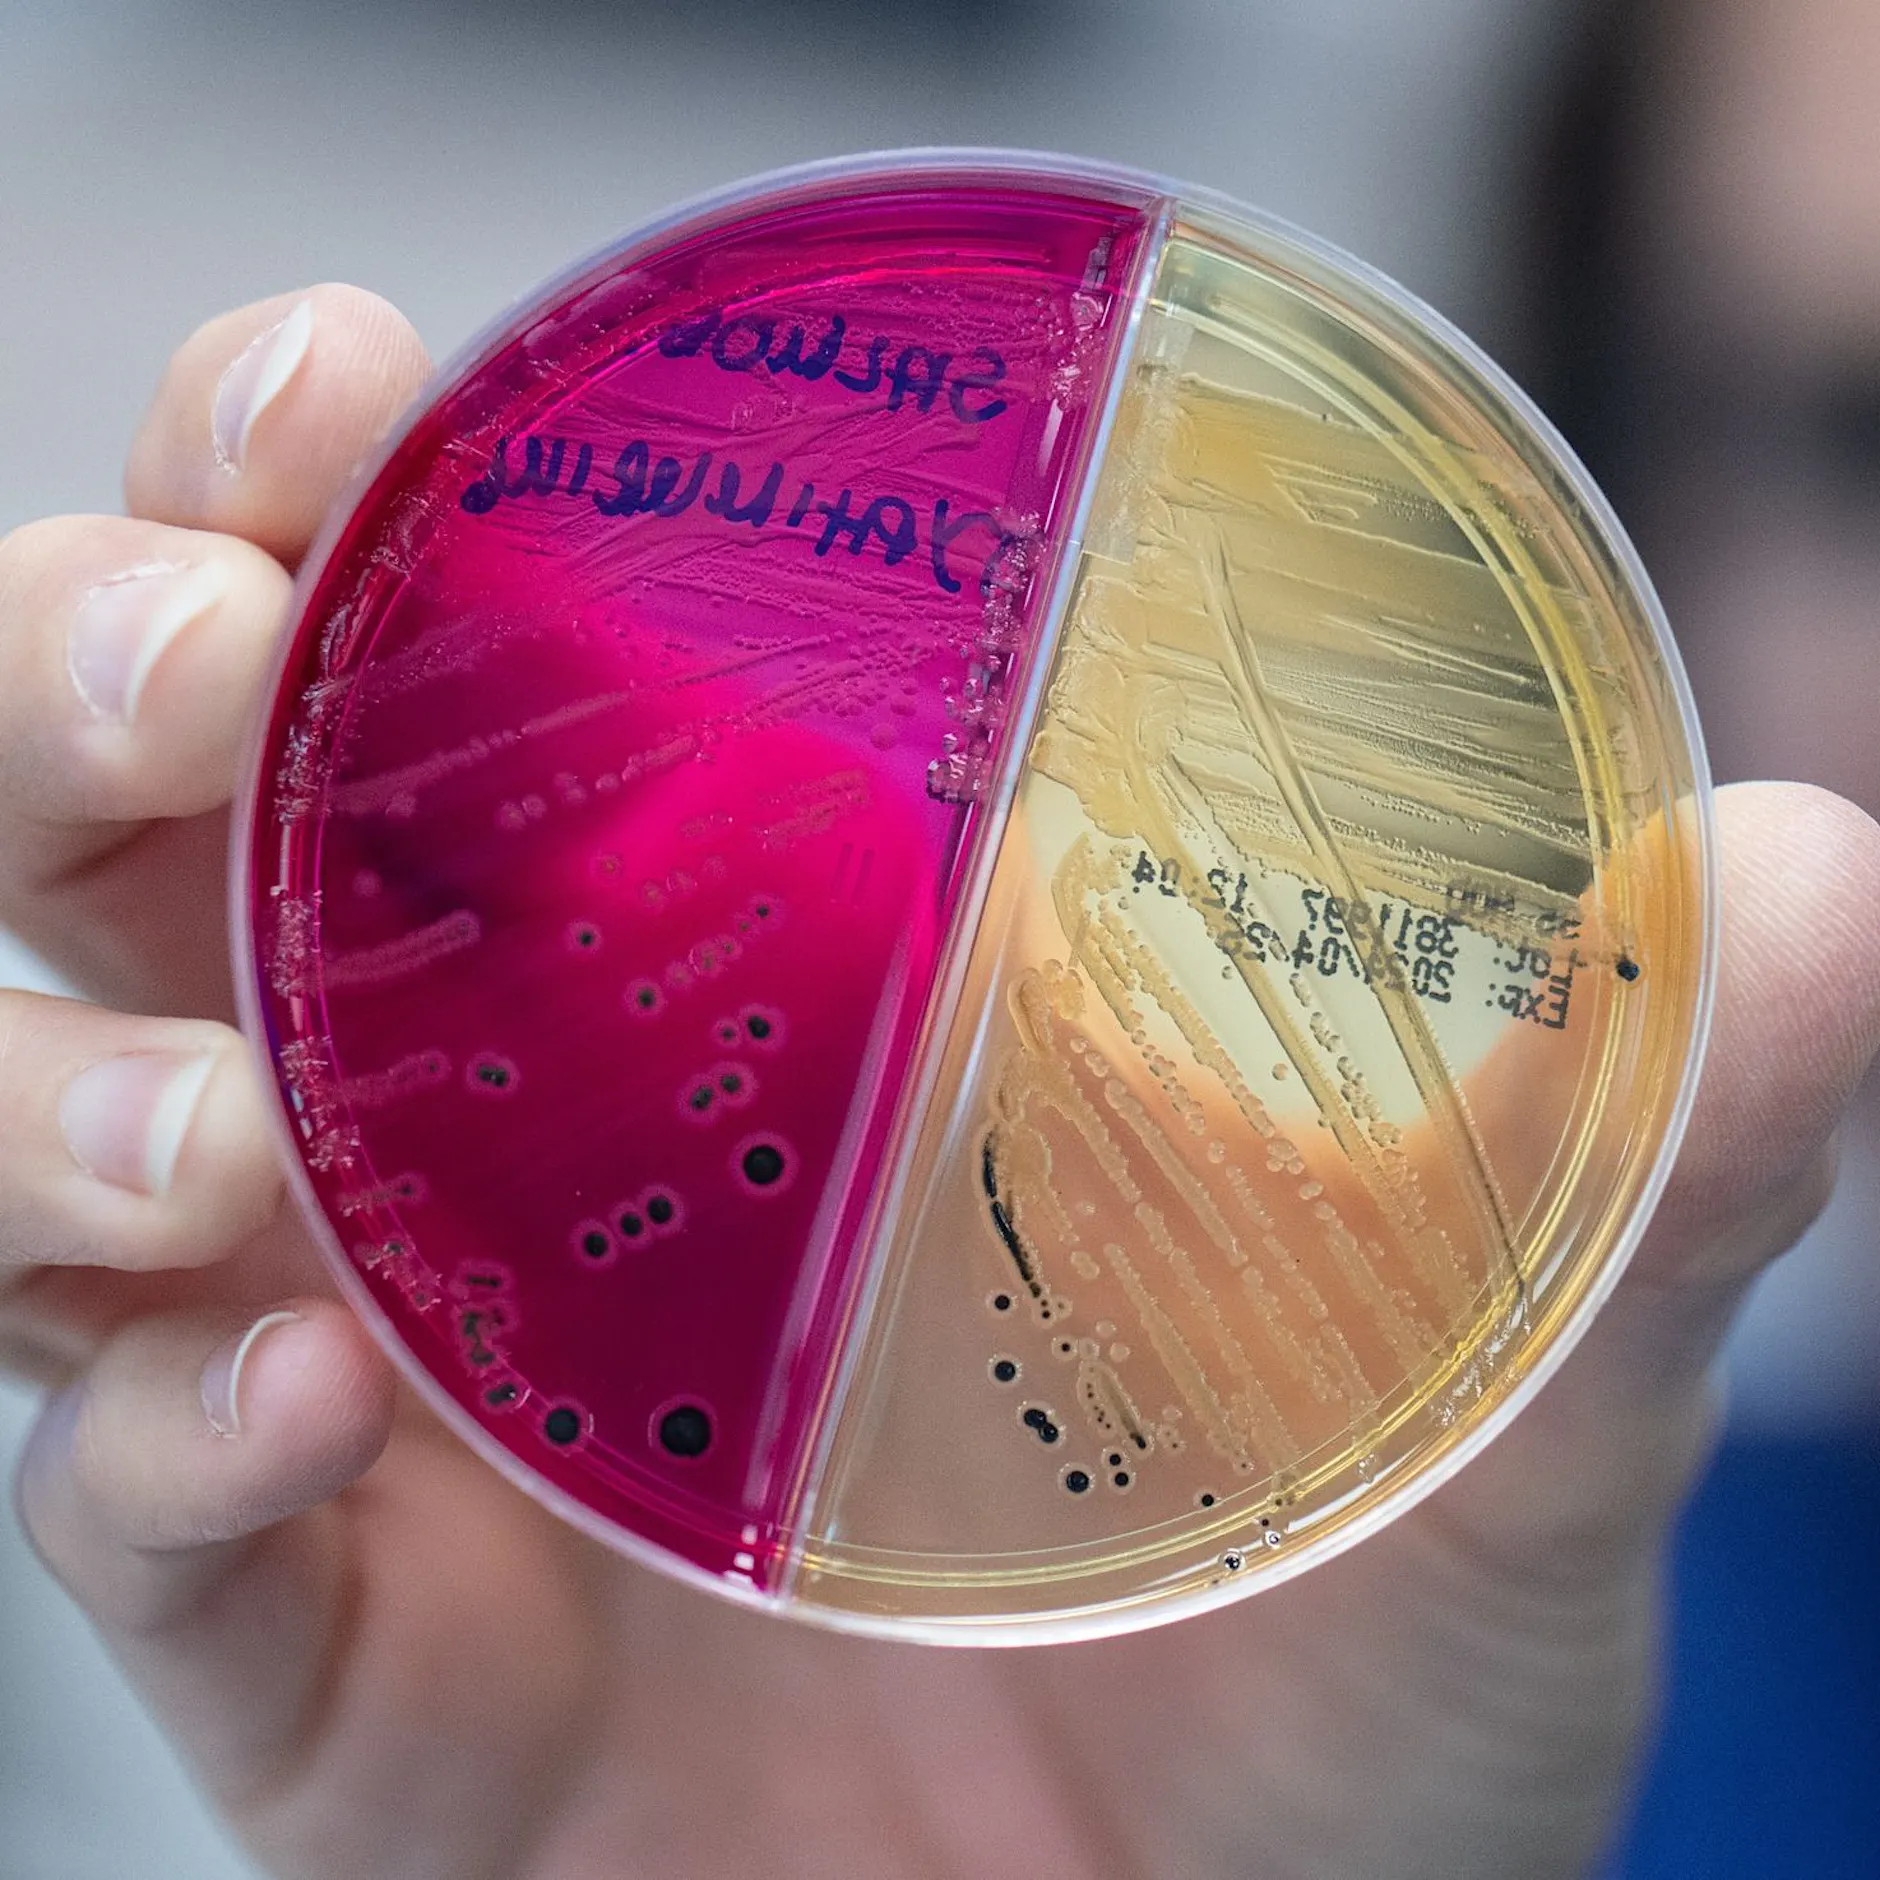
Detektivarbeit am Darm-Mikrobiom: Was Stuhlproben verraten

Der Geruch des Stuhlgangs kann ein Indikator für die Gesundheit sein. Während gelegentlicher Gestank nach dem Toilettengang normal ist, weisen bestimmte Geruchsnoten auf mögliche Erkrankungen hin, die einen Arztbesuch erforderlich machen.
Laut Angaben des Universitätsklinikums Augsburg besteht menschlicher Kot zu rund 75 Prozent aus Wasser. Weitere Bestandteile sind Ballaststoffe, abgestoßene Zellen der Darmschleimhaut, Bakterien, Schleim aus dem Magen-Darm-Trakt, unverdauliche Nahrungsreste sowie Gärungs- und Fäulnisprodukte. Farbe und Konsistenz variieren je nach Ernährung und Lebensstil stark, weshalb sich pauschale Aussagen über die Gesundheit anhand des Aussehens schwer treffen lassen. Anhand des Geruchs ist eine Einschätzung etwas einfacher.
Beißender Geruch deutet auf gestörten Ammoniak-Abbau hin
Riecht der Stuhlgang besonders beißend und chemisch, kann das nach Informationen des National Center for Biotechnology Information (NCBI) auf einen gestörten Ammoniak-Abbau im Darm hinweisen. Ammoniak, eine Verbindung aus Stickstoff und Wasserstoff, entsteht beim Verstoffwechseln tierischer Eiweiße im Darm. In einem gesunden Organismus wird dieser Stoff in unschädliches Ammoniaksalz umgewandelt.
Bei Erkrankungen der Leber oder Nieren kann diese Umwandlung gestört sein. Da beide Organe für den Abbau von Giftstoffen zuständig sind, sollten Betroffene bei einem solchen Geruch zeitnah ärztlichen Rat einholen.
Ein metallischer Geruch ist ein Warnzeichen, das auf Blut im Stuhl hindeuten kann. Blut aus dem Magen oder Darm kann den Stuhl schwarz bis dunkelrot färben und einen entsprechenden Geruch verursachen. Auch hier wird ein zeitnaher Arztbesuch empfohlen.
Faulig, sauer, süßlich – nicht immer ein Grund zur Sorge
Ein Geruch nach faulen Eiern entsteht meist nach dem Verzehr schwer verdaulicher Lebensmittel wie Fleisch, Milchprodukten oder Kohl und ist für sich genommen unbedenklich. Bleibt der Geruch jedoch auch nach Verzicht auf diese Speisen bestehen, kann eine Darmerkrankung wie die Divertikulitis dahinterstecken. Dabei sammeln sich Nahrungsreste in Ausstülpungen des Darms und verrotten dort.
Ein säuerlicher Geruch ist nicht zwangsläufig bedenklich. Tritt er allerdings in Kombination mit einer hellen und klebrigen Konsistenz auf, kann eine erkrankte Bauchspeicheldrüse oder eine chronische Darmentzündung die Ursache sein. Entscheidend ist die Dauer: Kurzfristig auftretende Gerüche sind in der Regel harmlos.
Süßlich riechender Stuhlgang bei Erwachsenen lässt sich häufig durch hohen Konsum zuckerhaltiger Lebensmittel wie Süßigkeiten, Obst, Fruchtsäften oder Süßstoffen erklären. Auch eine Laktoseintoleranz kann beim Verzehr von Milchprodukten neben Durchfall einen süßlichen Geruch verursachen. Hält dieser über einen längeren Zeitraum an oder treten zusätzliche Beschwerden wie Durchfall, Bauchschmerzen oder Gewichtsverlust auf, sollte ein Arzt konsultiert werden.
Fischgeruch kann auf seltene Stoffwechselerkrankung hindeuten
Ein fischartiger Geruch hat verschiedene mögliche Ursachen. Nach dem Verzehr von fettigem Fisch ist er harmlos und verschwindet von selbst. Steckt jedoch die seltene Stoffwechselerkrankung Trimethylaminurie (TMAU) dahinter, kann der Körper das Gas Trimethylamin nicht abbauen. Die genetisch bedingte Erkrankung führt nicht nur zu fischig riechendem Stuhl, sondern auch zu vergleichbaren Gerüchen auf der Haut und aus dem Mund. TMAU ist nicht heilbar, der Geruch lässt sich jedoch durch Therapiemethoden reduzieren.